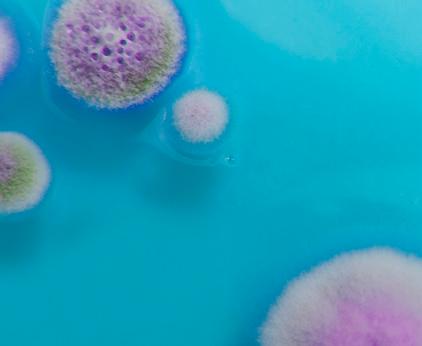

EPD 100/170/330 LGR LUFTENTFEUCHTER
Neue moderne Kondensentfeuchter mit LGR-Technologie.
Kompakte Größe, hohe Entfeuchtungsleistung und hohe Energieeffizienz.
Alle 3 Modelle jetzt mit voller Steuerung und Fernüberwachung über die kostenlose WiFi-app.
Mit umweltfreundlichem Kältemittel
KONDENSENTFEUCHTER DER LGR-SERIE (LOW GRAIN REFRIGERANT)
QR-CODE
Laden Sie die Bedienungsanleitung direkt über den QRCode auf dem Luftentfeuchter herunter.
Schadensanierung
Die Ecor Pro EPD-Modelle sind für ein breites Spektrum gewerblicher Anwendungen konzipiert, zielen jedoch insbesondere auf Schadenssanierungsunternehmen ab, wo sie aufgrund ihrer kompakten Bauweise, hohen Leistung und vielen positiven Eigenschaften beliebte Luftentfeuchter bei Überschwemmungen, Wasserund Feuchteschäden im Allgemeinen sind.
Produkteigenschaften/Vorteile:
• Verwendet das neue umweltfreundliche Kältemittel – R290.
• Große Trocknungskapazität im Verhältnis zur Größe dank LGR-Technologie – bis zu 150 l/Tag (EPD330).
• Ausgestattet mit kWh-Zähler.
• Energieeffizient mit optimalen Kompressorbetriebszeiten basierend auf einer internen Mikroprozessorberechnung zur Leistungsoptimierung.
• Bei einem Stromausfall startet der Luftentfeuchter automatisch.
Z.B. EPD170LGR
ECOR PRO – GLOBALER SPEZIALIST UND HERSTELLER MOBILEN ADSORPTIONSUND KONDENSENTFEUCHTERN
Mit Fokus auf Design, Leistung und lange Haltbarkeit entwickelt und produziert englische Ecor Pro Adsorptions- und Kondensentfeuchter, die im Bereich der professionellen Schadenssanierung kontinuierlich größere Marktanteile auf dem Weltmarkt gewinnen.
Die neuesten Ergänzungen sind die neuen hochmodernen Kondensentfeuchter EPD100LGR, EPD170LGR und EPD330LGR. LGR steht für "Low Grain Refrigerant". Ein normaler Kondensentfeuchter funktioniert nach einem sehr einfachen Prinzip. Ein Ventilator saugt feuchte Luft durch den Verdampfer, wo die Luft unter den Taupunkt abgekühlt wird. Der Wasserdampfanteil der Luft kondensiert an der kalten Oberfläche des Verdampfers und wird in einem Wassertank gesammelt oder über eine eingebaute Kondensatpumpe abgeleitet. Die kalte, trockene Luft strömt weiter durch den Kondensator, wo sie erwärmt und dann zurück in den Raum geblasen wird, wo sie bereit ist, neue Feuchtigkeit aus dem Raum aufzunehmen. Dieser Vorgang wird fortgesetzt, bis die gewünschte Luftfeuchtigkeit erreicht ist.
LGR-Technologie
Der Vorteil eines Kondensentfeuchters mit LGR-Technologie gegenüber herkömmlichen Kondensentfeuchtern besteht darin, dass er mit einem doppelten Kühlsystem arbeitet, welches die Luft vorkühlt und dadurch die Entfeuchtungsleistung erhöht. Die EPDXXXLGR-Serie verwendet zwei Kühlspulen, um die Luft vorzukühlen, bevor sie über die Kühlfläche (die kalte Oberfläche des Verdampfers) geleitet wird. Dies führt zu einer erhöhten Kondensatbildung und somit einer höheren Entfeuchtungsleistung.
• Rotorgeformte Kunststoffgehäuse widersteht rauer Behandlung.
• Wiegt ab nur 22 kg (EPD100). Einfacher Transport mit 2 Rädern.
• Kompakte Größe. Misst nur 37 cm in der Höhe (EPD100). Geeignet für Kriechkeller und Orte mit begrenztem Platz.
• Stapelbar für einfache Lagerung und Transport.
• Niedriger Schallpegel – ein Vorteil beim Betrieb in Wohnbereichen und anderen geräuschsensiblen Bereichen.
• Eingebaute, nahezu geräuschlose, automatische Kondensatpumpe mit eine Förderhöhe von 3,5 m.
• Geringer Stromverbrauch ab 2,1 A/475 W (EPD100).
• Leistungsstarkes Gebläse liefert bis zu 1.000 m3/Stunde (EPD330), schnelles Trocknen und perfekten statischen Druck für die Montage von Schläuchen.
• Auf den mitgelieferten Adapter Ø160 mm können Schläuche montiert werden für gezieltes Trocknen zB. Trockenkammer/ -zelt, unter Böden, in Hohlräumen usw.
• Elektronisches LCD-Kontroll- und Bedienpanel für verschiedene Funktionen.
• Wettbewerbsfähige Preise und Rabattsystem für Mengenkauf.
• Kostenlose WiFi-App für Android und Apple.
• Kompaktes Design.
• Misst nur 37 cm in der Höhe (EPD100).
• Geeignet für Kriechkeller und Orte mit begrenztem Platz.
Höhe ab nur 37 cm (EPD100LGR).
Geeignet für Kriechkeller und Orte mit begrenztem Platz.
4 Gummifüße, Klappgriff und 2 Räder für einfachen Transport Flache Füße ermöglichen das Stapeln und sorgen für Stabilität, stören aber nicht, wenn das Gerät über unebene Böden oder Treppen gezogen wird.
Kohlefilter
Äußerer Filterrahmen aus hartem Aluminium-Strangpressprofil, der mit einem kleinen Schraubendreher arretiert werden kann. Leicht zu reinigen und langlebig.
Einfache Reparatur
Seitenwände und obere Abdeckung lassen sich leicht entfernen, um für Reparaturund Wartungsarbeiten vollen Zugriff auf die Auffangwanne, die Wasserpumpe und andere elektrische Teile zu erhalten.
Upgrade im Juni 2025 mit kostenlosem WiFi EPHUM-I-MAX WiFi-Hygrostat, Controller und Datenlogger, der Ihnen die vollständige Kontrolle und Überwachung Ihres EcorPro EPDxxxLGR-Kondensentfeuchters ermöglicht.
INSTALLATION (2)
Schnellkupplung mit 12 m Ablaufschlauch
Installation of additional hose / dry air outlet
Das Kondensat der Pumpe wird durch einen Ablaufschlauch mit Schnellkupplung abgeleitet. Abnehmen/Anbringen in Sekunden. Versenkt, um das Risiko einer Beschädigung während des Transports zu verringern. Die Wasserpumpe kann bis zu einer Höhe von 3,5 m pumpen. Wird mit einem Ø7 mm Schlauch und einer Länge von 12 m verwendet.
An external hose can be optionally mounted on the discharge grille. This can be useful for certain drying requirements.
1) loosen the four screws of the air outlet channel
2) replace the adapter turned
3) attach the hose to the adapter
Spanngurten
Mit Spanngurten können Netzkabel und Kondensatschlauch einfach befestigt werden.
Installieren des Schlauchbeutel-Adapters
Schläuche/Schlauchbeutel können auf dem mitgelieferten Adapter (Ø160 mm) montiert werden, um z.B. gezielt zu trocknen. Trockenkammer/-zelt, unter Böden, in Hohlräumen usw.
Klappgriff
FAKTEN LGR-SERIE
Allgemeine
Stromversorgung 220-240 V, 50 Hz
Stromkabel 5 m
Ablaufschlauch 12 m
Betriebstemperatur 1 - 38 °C
Modell
Abmessungen (B x H x L) / Gewicht 31 x 37 x 50 cm / 22 kg
Entfeuchtungsleistung:
60% relative
Kältemittel R290, 135 g
Nennleistung / Strom
für Schläuche
OPERATION AND SETTINGS
x
x
x
cm / 45 kg
BEDIENFELD - GEBRAUCHSANLEITUNG
Control panel
Ein/Aus
HUMIDISTAT MODE (Hygrostat)
Menu - Display screen - On/off button
Auspumpen
Menu selection / Up - Pump button
Main Menu - Display
Insert plug into earthed socket When the unit is connected, it starts the diagnostic procedure.
Drücken Sie die PUMP-Taste. Das Gerät pumpt 50 Sekunden lang, um das Wasser manuell aus dem Kondensatpumpenbehälter abzulassen. Im Normalbetrieb wird 90 Sekunden lang abgepumpt, wenn der Behälter voll ist. In der oberen rechten Ecke des Displays blinkt ein P.
The display shows “self diagnosis”. When the unit is ready, the display shows “stand by”.
JOBS HOURS
Gesamtzahl der Betriebsstunden für eine bestimmte Aufgabe.
LIFE HOURS
Switching the unit on/off
Drücken Sie die Taste MENÜAUSWAHL und stellen Sie "Humidistat Mode" auf "ON" um den eingestellten Wert von CO-35-40-45-50-55-60-65-7075-80-85-90 % anzupassen. Wählen Sie den gewünschten Wert und warten Sie 5 Sekunden – die Einstellung wird gespeichert. CO bedeutet kontinuierliche Entfeuchtung.
INLET OUTLET
Zeigt die aktuelle Temperatur und relative Luftfeuchtigkeit des Ein- und Auslasses an.
Press the “on/off” button. The unit starts up, the display shows “unit on”.
Zeigt die Gesamtzahl der Betriebsstunden an. Der Wert kann nicht geändert werden.
COIL TEMP
Operating time 00:00, set value (00%), current temperature 00 oC and current humidity 00%.
Zeigt die Temperatur der Kühlspule an. ENERGY METER Misst den Stromverbrauch in kWh.
COMPRSS CURRENT
Zeigt die Stromaufnahme in Ampere an.
Fehlermeldungen
Wenn die integrierte Diagnose des Geräts ein Problem erkennt, zeigt das Gerät einen Fehlercode an.
NIEDRIGSTER
CO2-FUSSABDRUCK
Martin Gray – CEO und Inhaber von Ecor Pro erklärt:
"Wir setzen uns für die Reduzierung unserer Umweltbelastung ein und sind uns bewusst, dass die Umweltleistung für den Erfolg unseres Unternehmens von entscheidender Bedeutung ist.
Unsere Ingenieure sind in Großbritannien ansässig, kennen sich aber bestens mit dem Weltmarkt aus.
Die Bedeutung der Anwendung bewährter Umweltpraktiken ist in unserer Unternehmenskultur verankert.
Wir behaupten nicht, die Größten zu sein. Unser Ziel ist es, der effizienteste Hersteller zu sein. In Zeiten des Klimawandels und steigender Energiekosten ist es unser unveränderliches Ziel, sicherzustellen, dass der Energieverbrauch für die Extraktion eines Liters Flüssigkeit geringer ist als der der Maschinen unserer Wettbewerber.
Wir kompensieren den CO2-Fußabdruck unserer Produkte, indem wir Bäume schützen, die Kohlenstoff aus der Atmosphäre aufnehmen und speichern. Bäume zu pflanzen ist zwar lobenswert, aber der gespeicherte Kohlenstoff geht verloren, sobald die Bäume gefällt werden. Bei Ecor Pro zahlen wir für den Schutz der Bäume und ermöglichen ihnen ein langes und schönes Leben als Kohlenstoffspeicher. Und wir senden nicht einfach nur Geld ins Ausland und hoffen, dass wir damit die Daumen drücken. Wir zahlen für den Schutz eines Waldes in Wales, damit wir wissen, dass unsere Spende zur Rettung des Planeten beiträgt. Denn das ist wichtig. Wenn wir für dieselbe Arbeit weniger Strom verbrauchen, sparen wir nicht nur direkt Kosten für unsere Kunden, sondern tragen auch zum Schutz unseres Planeten bei. Außerdem achten wir sehr genau auf die Langlebigkeit unserer Produkte. Ein wichtiger Grund, warum Kunden zu uns kommen, ist, dass sie mit der Anzahl der Mängel früherer Produkte oder deren kurzer Lebensdauer unzufrieden waren.
Indem wir die Nachhaltigkeit unserer Produkte in der Lieferkette gewährleisten und Kosten senken, können wir es uns leisten, Produkte nicht billiger zu machen, sondern dort Mehrwert zu schaffen, wo es darauf ankommt. Ein Produkt muss dauerhaft funktionieren und im Schadensfall schnell und einfach zu reparieren sein. Kurz gesagt: Genau das bieten Ecor Pro Luftentfeuchter."
In die Zukunft investieren
Ecor Pro ist sich der moralischen Verpflichtung gegenüber der Zukunft unseres Planeten bewusst. Wir hoffen, dass unsere Arbeit der Welt eine bessere Zukunft.
Kreislaufwirtschaft
ÜBER ECOR PRO
Mit Fokus auf Design, Leistung und Langlebigkeit entwickelt und produziert Ecor Pro Adsorptionsund Kondensentfeuchter, die weltweit in der professionellen Schadensanierung, der Industrie, dem privaten Sektor usw. kontinuierlich Marktanteile gewinnen.
Die energieeffizientesten Produkte
Wir entwickeln Designs, die die maximale Wassermenge aus der eingesetzten Energie gewinnen. Effizient und zweckdienlich.
Jedes Produkt pflanzt einen Baum
Für jedes unserer Produkte wird ein Baum gepflanzt oder geschützt. Wir kompensieren den CO2-Fuß-abdruck unserer Produktion.
IHR TRANSPORTER WIRD NICHT GRÖSSER! GIBT ES PLATZ FÜR IHRE GESAMTE AUSRÜSTUNG UND MATERIALIEN?
Die Durchführung von Dienstleistungen in der Schadensanierung erfordert eine Menge technischer Geräte, Hilfsmittel, Chemikalien usw. Es ist weder besonders wirtschaftlich noch besonders „klimafreundlich“, mehrmals zwischen Schadenort und Lager hin- und herfahren zu müssen, um die benötigte Ausrüstung abzuholen.
Herkömmliche Luftentfeuchter benötigen viel Platz und da Transportere nicht gerade größer werden, sind kompakte und platzsparende Luftentfeuchter erforderlich. In der Schadensanierung ist es äußerst wichtig, dass die Fahrzeuge optimal eingerichtet und beladen sind, um die für den Einsatz erforderliche Ausrüstung transportieren zu können.
Die LGR-Serie ist äußerst kompakt und stapelbar Die neue Serie kompakter LGR-Luftentfeuchter von Ecor Pro ermöglicht den Transport VIELER Luftentfeuchter.
Als Beispiel dient hier einer der in der Schadenssanierung gängigen Service-Transporter, nämlich ein Ford Transit Custom, niedriges Modell und hohes Modell.
Jeder Mitarbeiter in der Schadensanierung wird das kompakte Design, das geringe Gewicht und die Stapelbarkeit dieser Luftentfeuchter für den Transport zum und vom Schadensort zu schätzen wissen. Darüber hinaus sind diese modernen Luftentfeuchter mit robusten Gummirädern, Klappgriffen und ergonomischen Seitengriffen zum Anheben ausgestattet. Alle diese Funktionen erleichtern den Transport über Treppen, entlang von Fußböden, in und aus Kriechkellern und an alle anderen Orte mit begrenztem Platz.
Das Bild links zeigt, dass im Heck eines Ford Transit Custom 12 x EPD100LGR Platz finden – das kleinste Modell der Kondensentfeuchter.
Das Bild unten zeigt, dass in dasselbe Auto problemlos 9 kompakte und stapelbare EPD170LGR passen.
KOMPAKTES DESIGN ENERGIEEFFIZIENT
NIEDRIGE ENERGIEKOSTEN UND NIEDRIGSTER CO2-FUSSABDRUCK
Ecor Pro EPDXXXLGR-Luftentfeuchter sind effizienter und erzeugen trockenere Luft (niedrigere relative Luftfeuchtigkeit, RH) als herkömmliche Kondensentfeuchter.
Kondensentfeuchter vom Typ Ecor Pro EPDXXXLGR verwenden zwei Verdampferspulen, um den Taupunkt der Luft zu senken, statt nur einer wie bei herkömmlichen Kondensentfeuchtern.
Dieses neue Design des Kühlsystems, kombiniert mit einem modernen Niedrigenergie-Schraubenkompressor und ein Lüftermotor, der die neuesten Effizienzkriterien für Ventilatoren erfüllt, machen die neuen und hoch energieeffizienten Kondensentfeuchter EPDXXXLGR von Ecor Pro aus.
(kalt) (warm)
Diagramm des Kühlsystems in einem EPDXXXLGR-Kondensentfeuchter.
Was bedeutet es, den effizientesten Luftentfeuchter zu haben?
Weitere Luftentfeuchter
Der geringe Verbrauch ermöglicht mehrerer Luftentfeuchter an derselben Steckdose.
Kürzere Trocknungszeit
Schnellere Entfeuchtung bei gleichem Stromverbrauch.
Niedrigere Energiekosten für den Hausbesitzer oder die Versicherungsgesellschaft.
Bedarf an weniger Luftentfeuchtern
Kleine Transporter können die gleiche Trocknungsleistung transportieren.
ECOR PRO LGR KONDENSENTFEUCHTER IN MEHREREN FARBEN!
Der erste Eindruck eines Unternehmens und seiner Marke soll angeblich auf den verwendeten Farben und Symbolen beruhen. Ecor Pro bietet seine neuen und modernen LGR-Kondensentfeuchter jetzt auf Bestellung in der Farbe an, die zu Ihrem Unternehmen passt. Die Standardfarbe ist Gelb. Kontaktieren Sie NAC für weitere Informationen.
Welche Farbe sollte Ihr Ecor Pro Kondensentfeuchter haben?
KLEINE GRÖßE GROßE LEISTUNG
WELCHE
TROCKNUNGSTECHNOLOGIE SOLLTEN SIE VERWENDEN? KOMBINIEREN SIE DIE RICHTIGE AUSRÜSTUNG FÜR OPTIMALE ERGEBNISSE
Die Wahl der richtigen Trocknungstechnologie hängt von verschiedenen Faktoren ab, wie Lufttemperatur, Luftfeuchtigkeit, Umgebung, Baumaterialien, Baukonstruktionen etc.
bietet verschiedene Entfeuchtungstechniken an: Infrarot-Technologie mit Heizpaneelen (WMT DryPanel) NAC formbare elektrische Heizmatten (EHM), sorptions- und kondensentfeuchtung (Ecor Pro).
Kontaktieren Sie NAC – wir haben die passende Trocknungstechnologie für Sie.
ECOR PRO – Globaler Spezialist für Entfeuchtungstechnik
Mit dem Fokus auf Design, Leistung und langer Lebensdauer entwickelt Ecor Pro Adsorptions- und Kondensentfeuchter, die in der professionellen Schadensanierung, in der Industrie, im privaten Sektor usw. kontinuierlich größere Marktanteile auf dem Weltmarkt gewinnen.
DH2500 DryFan 35L / DH3500 DryFan 45L Adsorptionsentfeuchter
EPD150-RESTO – DryFan 35L Adsorptionsentfeuchter
SCHADENSANIERUNG, KÜHL-/GEFRIERRÄUME, INDUSTRIE ALLGEMEIN, ETC.
Entwickelt für den 24/7-Einsatz in rauen Umgebungen mit niedrigen Energiekosten und geringstem CO2-Fußabdruck.
HAUS, GARAGE, FERIENHAUS USW.
EPD50-RESTO – DryFan 13L Adsorptionsentfeuchter WMT DryPanels – Infrarot-Wärmetrocknung
EPD100/170/330LGR Neuer LGR Kondensentfeuchter
Für überall im Haus, vom Dachboden bis zum Keller. Rund um die Uhr – ohne aufsicht – nur ein handelsüblicher Luftentfeuchter ist dafür geeignet.
SCHWIMMBAD, UMKLEIDERAUM
Speziell beschichtet und geschützt für den Einsatz in Schwimmbädern oder Umkleidekabinen, damit das Chlor in der Luft das Gerät nicht beschädigt.
NAC Elektrische Heizmatten Flexibel und formbar
HANDELSSCHIFFE UND YACHTEN
Bootsentfeuchter bestehen zum Schutz vor Salzwasser innen und außen aus rostfreiem Stahl. Sie funktionieren bei jeder Temperatur und sind unempfindlich gegen Kippen oder Rollen.